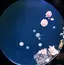
愛香のプロフィール画像

Eyelash Salon Blanc ~まつげエクステと眉の専門美容室~ 和歌山ミオ店栖井 杏
アシスタント/研修歴 1年
- 仕上がり満足度が高い91%のお客様が高い評価をつけています
- サービス満足度が高い95%のお客様が高い評価をつけています

口コミ・評判
仕上がり・技術
4.6コミュニケーション・サービス
4.8ミニモでの対応
4.8
19件の口コミ中1〜19件表示
愛香さんの口コミ
女性 / 20代前半
声掛けを沢山して下さったので安心してうけられました!しみることもなく仕上がりにも満足していますありがとうございました!
来店日:2025年11月7日来店回数:2回
yさんの口コミ
女性 / 30代後半
まつ毛が少なく短くてやりにくかったと思います。 接客は大変気持ちがよく、これからも頑張って下さい。応援しています。
来店日:2025年10月22日
まぁさんの口コミ
女性 / 50代後半
カウンセリングから施術まで、きちんと丁寧に対応してくださいました。先輩の指導を受けながらしていただいたので、きっちりしていただけて尚良かったです。
来店日:2025年10月21日来店回数:2回
ゆいさんの口コミ
女性 / 20代後半
眉、まつ毛ともにとても綺麗に仕上げてくださいました!大満足です!ありがとうございました🥺
来店日:2025年8月12日来店回数:2回
aさんの口コミ
女性 / 30代前半
昨日はありがとうございました。 いつもきれいな仕上がり、とても嬉しいです☺️
来店日:2025年7月27日来店回数:2回
ゆさんの口コミ
女性 / 10代後半
とても丁寧に対応して下さいました! 仕上がりも綺麗で満足です。 ありがとうございました✨✨
来店日:2025年7月15日
まぁさんの口コミ
女性 / 50代後半
とても丁寧にしていただきました。 仕上がりも希望通り綺麗にしていただきありがとうございました。 是非またよろしくお願いします。
来店日:2025年6月17日来店回数:2回
◡̈❤︎さんの口コミ
女性 / 30代前半
接客がとても丁寧でした。眉毛もマツパも染みることも痛さも全くなく快適に過ごせました。美眉スタイリングは初めてでしたが、形が整えられて化粧の時間が短縮されそうです。マツパも希望通り、根本からくっきり上がっていて満足しています。本日はありがとうございました。
来店日:2025年6月13日
はりふさんの口コミ
女性
丁寧に施術していただき感謝です。 心地良過ぎて寝過ぎました。 ありがとうございました☺︎
来店日:2025年6月5日
あさんの口コミ
女性 / 10代後半
めっちゃ可愛かったです!ありがとうこざいます!
来店日:2025年6月4日
あきらさんの口コミ
女性 / 20代前半
施術して頂きありがとうございました☺️ 丁寧な接遇と満足できた仕上がりで気持ちも見た目も最高です𖠶ˬ𖠶🤍
来店日:2025年5月12日
りにゃさんの口コミ
女性 / 20代前半
とても丁寧にカウンセリングしていただき、理想の仕上がりでした✨️本当にありがとうございました!
来店日:2025年5月8日
トッティーさんの口コミ
女性
施術前に説明をしっかりして下さり言葉遣いも丁寧で先輩の方のチェックもまめにあり、安心しておまかせ出来ました まゆのお手入れは今までも経験ありますが1番上手だった様な気がします いつデビューしてもいいくらいだと思います 黒い器具(定規?!)の時に鼻にちょこちょこ当たるのが違和感だったくらいで大満足です 毎日のメイクが楽しくて仕方ないです ありがとうございました 買わせて頂いたT3 LABO EXOSOMEの効果も今後楽しみです!!!
来店日:2025年5月7日
あさんの口コミ
女性 / 20代前半
丁寧なカウンセリングをしていただき、眉毛の左右差もなく、自然で美しい形に整えていただきました。まつ毛も目尻から上がっていて、仕上がりにとても満足しています。スタッフの方の対応もとても親切で、リラックスできる時間を過ごせました。
来店日:2025年5月7日
sakuさんの口コミ
女性
優しい雰囲気でありつつ、丁寧なカウンセリングと接客でした。眉の左右バランスを整えてもらったので描きやすくなりました。ありがとうございました。
来店日:2025年4月25日
るるさんの口コミ
女性 / 30代後半
丁寧に綺麗に仕上げていただきました。ありがとうこざいました。
来店日:2025年4月20日
Kさんの口コミ
女性 / 30代後半
綺麗な形に仕上げていただき、メイクがしやすくなりました☺️ ありがとうございました☺️✨
来店日:2025年4月20日
(^^)さんの口コミ
女性 / 20代前半
すごく丁寧な対応で、したかったまつ毛に知れくれてすごく嬉しいです^_^ また行きますっ
来店日:2025年4月19日
栖井 杏さんからの返信
本日はありがとうございました!^ ^ 嬉しい口コミもありがとうございます!😊 喜んでいただけてとても嬉しく思っております!☺︎ またのご来店お待ちしております!☺️⭐️
返信日:2025年4月19日
モッさんの口コミ
女性 / 30代後半
優しくて丁寧な接客と施術をしてもらいました まつげカールも綺麗にしてもらい周りの評判も良いです😊
来店日:2025年4月11日
栖井 杏さんからの返信
先日はありがとうございました!😊 嬉しい口コミもありがとうございます^ ^ 気に入っていただけて嬉しいです☺️⭐️ また是非よろしくお願いいたします!☺︎
返信日:2025年4月19日
- 1
掲載されている口コミは、当サイトの見解ではなく、ユーザーによる主観的なご意見であり、その正確性を保証しません。上記の口コミはあくまでも一つの参考としてご活用ください。

